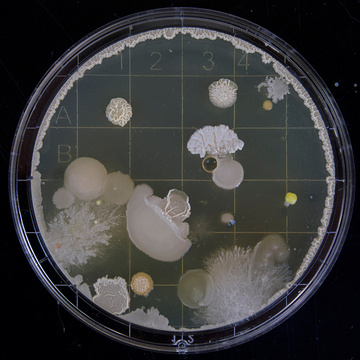

notopygos
Notopygos
https://tilde.town/~notopygos
Internet
Browse others (14)
|
|
oleksiv Oleksandr Ivanov |

|
darfk Thomas Payne |

|
missnails Nails⚒️777 |

|
busybeingawesome Brian Beck |

|
pandashatoshi PandaShatoshi |

|
apreseau Addie |

|
sarairene13 Sara Vath |

|
kinash Alexander |
|
|
nfhmooney Hugh Mooney |

|
sasho Sasho Andrijeski |